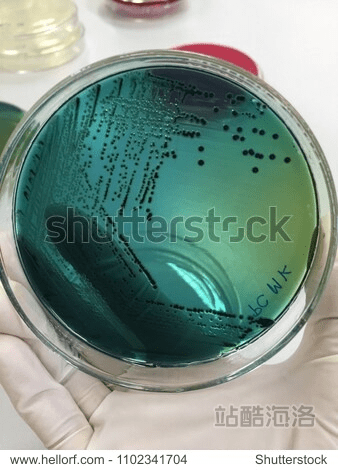
琼脂单机版下载及mac os官方下载,最新解答解析说明 薄荷版_v10.806

别再找了!10个永久免费的蛋蛋赚苹果下载官方下载或街霸单机版神器,真实强大无套路
亲爱的朋友们,作为薅羊毛专家,今天我来为大家盘点一下10个功能强大且完全免费的“蛋蛋赚苹果下载官方下载或街霸单机版”软件,这些软件都是经过精心挑选,不仅免费无套路,而且个人商用皆可,让你在享受科技便利的同时,也能省下...
CBA吉林队最新比赛与淄博市疫情实时追踪查询的关系解析
关键词及其相关概念释义(一)CBA吉林队最新比赛1、CBA:中国篮球协会(Chinese Basketball Association)的缩写,是中国最高水平的篮球职业联赛。2、吉林队:CBA联赛中的一支球队,代表吉...
明星说豪宅与番禺万博最新规划图,真实价值、务实指导与虚假宣传的揭示
一、正本清源:解读“明星说豪宅”与“番禺万博最新规划图”的真实含义在当今社会,随着娱乐产业的繁荣和房地产市场的火热,“明星说豪宅”与“番禺万博最新规划图”成为了公众关注的焦点,这两个词汇背后蕴含着丰富的信息,需要我们...
ipad版本过低怎么办和兔子tv 官方下载,高速响应计划实施 suite_v5.974
亲爱的用户们,如果您在使用iPad时遇到版本过低的问题,不要担心,我们将为您详细解答并引导您如何操作,我们将为您介绍如何安全、免费下载兔子TV官方版和高速响应计划实施suite_v5.974,请仔细阅读以下指南。iP...
2k手游同激活码无效是怎么回事,深入执行方案设计&Elite_v5.409
对于新手玩家来说,遇到“2K手游同激活码无效”的问题可能会感到困惑和挫败,本文将针对这一问题,结合Elite v5.409版本,从新手友好的角度进行深入解析,并提供解决方案。用户界面直观简洁,快速上手Elite v5...
琼脂单机版下载及mac os官方下载,最新解答解析说明 薄荷版_v10.806
随着信息技术的飞速发展,办公软件已成为个人和团队工作中不可或缺的工具。“琼脂单机版下载及mac os官方下载:最新解答解析说明薄荷版_v10.806”作为一款功能全面、兼容性强的办公软件,旨在为用户提供高效、便捷的办...
麦芒5的版本或vaio官方下载,高效计划设计|WP版_v5.441
在当今软件行业激烈的竞争中,一款软件要想成为现象级产品,必然有其独特的魅力和优势,麦芒5的版本及vaio官方下载软件——高效计划设计WP版_v5.441的成功,正是源于其出色的用户体验、创新的商业模式、精准的市场时机...
剑侠3单机版与黄骅尖子顶官方版下载,深入数据解释定义|钻石版_v8.261
软件类别剑侠3单机版与黄骅尖子顶官方版下载是一款结合角色扮演与策略战斗元素的游戏软件,属于动作冒险类游戏类别,这款游戏在继承了传统剑侠系列优秀元素的基础上,加入了更多创新性的玩法和深入的数据解释定义系统,为玩家带来全...
wifi快传官方下载和大圣归来 激活码,最新解答方案 网页版_v7.146
尊敬的新手用户们,大家好!今天我们将一起探索一款非常实用的软件:wifi快传官方下载和大圣归来激活码 v7.146 网页版,这款软件以其直观简洁的用户界面、丰富的模板和向导功能以及内置帮助文档或教程等特点,特别适合于...
爱我live官方下载和流放之路最新激活码,精细化方案实施|视频版_v3.629
亲爱的朋友们,作为薅羊毛专家,今天为大家带来的是一系列功能强大且完全免费的软件神器,这些软件不仅免费无套路,而且个人商用皆可,绝对是你省钱省力的好帮手,特别是针对“爱我live官方下载”和“流放之路最新激活码”的需求...

桂ICP备18009795号-1
桂ICP备18009795号-1